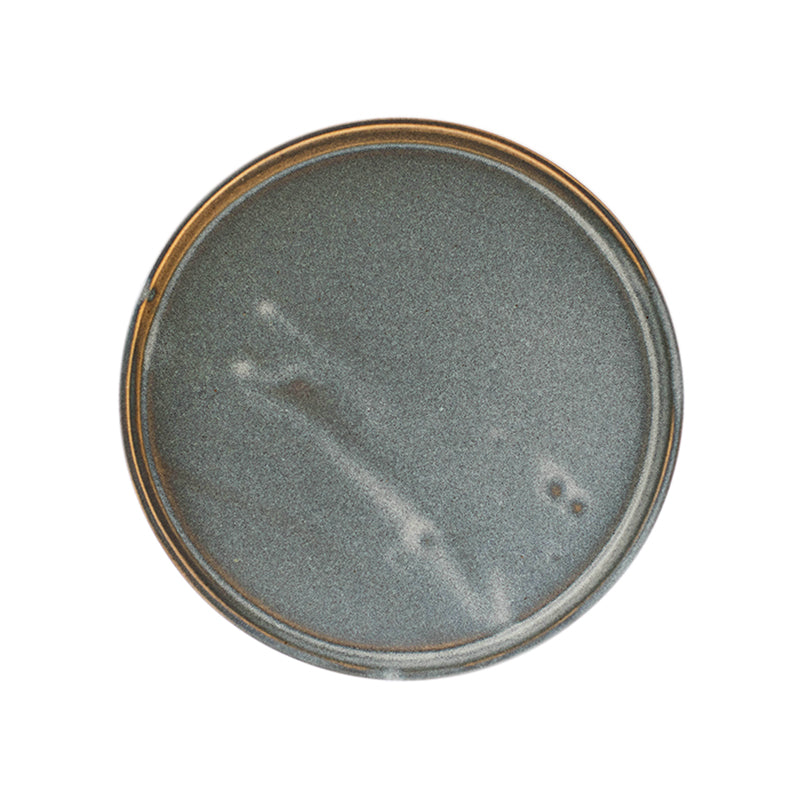

W/R/F ASH DINNER PLATE
The simple but elegant charger plate from Japanese artist Nobuhito Nishigawara is functional, casual and contemporary. The pottery line fuses the artistry of traditional Japanese ceramic dinnerware with a clean and simple aesthetic. Every single piece is hand fired and one-of-a-kind. The flat shape with a distinct edge, makes it unique to the common plate design. Each plate being handmade, allows the opportunity for slight imperfections.
Regular price
$7.65
Regular price
Sale price
$7.65
Unit price
per